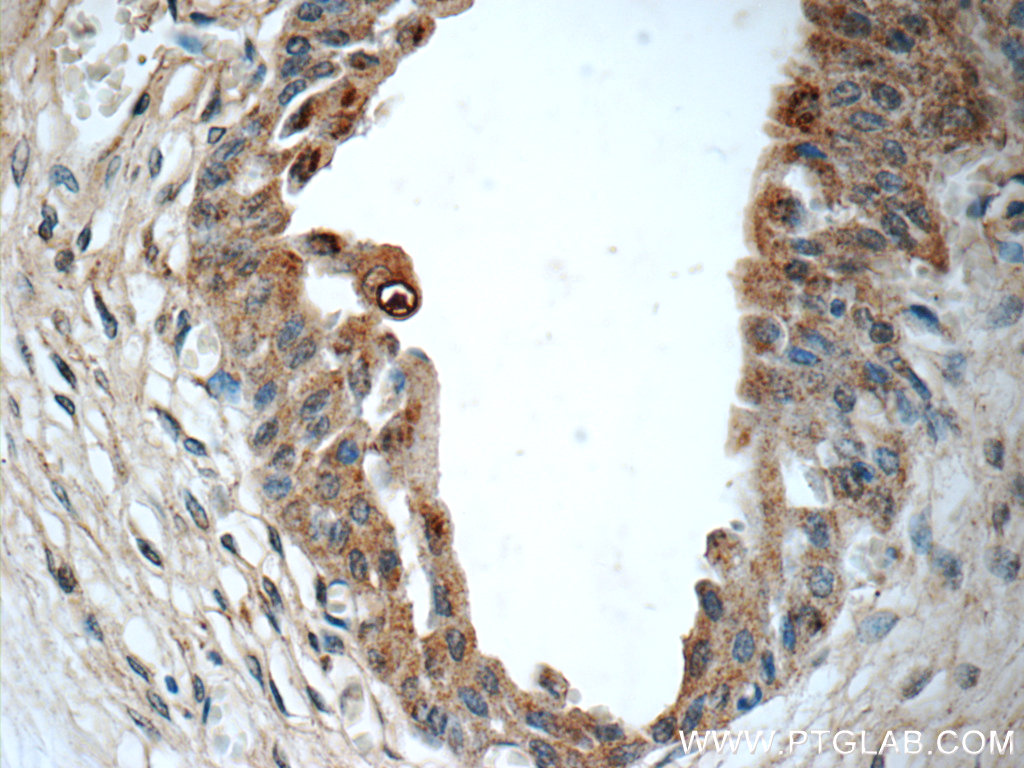

验证数据展示
经过测试的应用
| Positive WB detected in | MCF-7 cells, HEK-293 cells |
| Positive IP detected in | HEK-293 cells |
| Positive IHC detected in | human kidney tissue, human bladder tissue, human renal cell carcinoma tissue Note: suggested antigen retrieval with TE buffer pH 9.0; (*) Alternatively, antigen retrieval may be performed with citrate buffer pH 6.0 |
| Positive IF/ICC detected in | HeLa cells |
推荐稀释比
| 应用 | 推荐稀释比 |
|---|---|
| Western Blot (WB) | WB : 1:500-1:2000 |
| Immunoprecipitation (IP) | IP : 0.5-4.0 ug for 1.0-3.0 mg of total protein lysate |
| Immunohistochemistry (IHC) | IHC : 1:50-1:500 |
| Immunofluorescence (IF)/ICC | IF/ICC : 1:50-1:500 |
| It is recommended that this reagent should be titrated in each testing system to obtain optimal results. | |
| Sample-dependent, Check data in validation data gallery. | |
产品信息
12221-1-AP targets BMP7 in WB, IHC, IF/ICC, IP, ELISA applications and shows reactivity with human samples.
| 经测试应用 | WB, IHC, IF/ICC, IP, ELISA Application Description |
| 文献引用应用 | WB, IHC, IF, IP |
| 经测试反应性 | human |
| 文献引用反应性 | human, rat |
| 免疫原 |
CatNo: Ag2902 Product name: Recombinant human BMP7 protein Source: e coli.-derived, PGEX-4T Tag: GST Domain: 82-431 aa of BC008584 Sequence: FMLDLYNAMAVEEGGGPGGQGFSYPYKAVFSTQGPPLASLQDSHFLTDADMVMSFVNLVEHDKEFFHPRYHHREFRFDLSKIPEGEAVTAAEFRIYKDYIRERFDNETFRISVYQVLQEHLGRESDLFLLDSRTLWASEEGWLVFDITATSNHWVVNPRHNLGLQLSVETLDGQSINPKLAGLIGRHGPQNKQPFMVAFFKATEVHFRSIRSTGSKQRSQNRSKTPKNQEALRMANVAENSSSDQRQACKKHELYVSFRDLGWQDWIIAPEGYAAYYCEGECAFPLNSYMNATNHAIVQTLVHFINPETVPKPCCAPTQLNAISVLYFDDSSNVILKKYRNMVVRACGCH 种属同源性预测 |
| 宿主/亚型 | Rabbit / IgG |
| 抗体类别 | Polyclonal |
| 产品类型 | Antibody |
| 全称 | bone morphogenetic protein 7 |
| 别名 | OP1, OP 1, Eptotermin alfa, Bone morphogenetic protein 7, BMP-7 |
| 计算分子量 | 431 aa, 49 kDa |
| 观测分子量 | 43-49 kDa |
| GenBank蛋白编号 | BC008584 |
| 基因名称 | BMP7 |
| Gene ID (NCBI) | 655 |
| RRID | AB_2063960 |
| 偶联类型 | Unconjugated |
| 形式 | Liquid |
| 纯化方式 | Antigen affinity purification |
| UNIPROT ID | P18075 |
| 储存缓冲液 | PBS with 0.02% sodium azide and 50% glycerol, pH 7.3. |
| 储存条件 | Store at -20°C. Stable for one year after shipment. Aliquoting is unnecessary for -20oC storage. |
背景介绍
The bone morphogenetic proteins (BMPs) are a family of secreted signaling molecules that can induce ectopic bone growth. Many BMPs are part of the transforming growth factor-beta (TGFB) superfamily. BMPs were originally identified by an ability of demineralized bone extract to induce endochondral osteogenesis in vivo in an extraskeletal site.
BMP7, also known as osteogenic protein-1 or OP-1, plays a key role in the transformation of mesenchymal cells into bone and cartilage. BMP7 may be involved in bone homeostasis (PMID: 15621726). It is expressed in the brain, kidneys and bladder. BMP7 is also present in cancers, including breast, prostate, and colon cancers, in which it is implicated in regulating cancer cell proliferation (PMID: 16419056, PMID: 15531927). Overexpression of BMP7 mRNA in colorectal cancer patients was significantly associated with poor prognosis and low overall survival (PMID: 18259822). Recent studies suggest that high-expression level of BMP7 serves as a biomarker for poor prognosis for HCC (PMID: 23179403).
实验方案
| Product Specific Protocols | |
|---|---|
| IF protocol for BMP7 antibody 12221-1-AP | Download protocol |
| IHC protocol for BMP7 antibody 12221-1-AP | Download protocol |
| IP protocol for BMP7 antibody 12221-1-AP | Download protocol |
| WB protocol for BMP7 antibody 12221-1-AP | Download protocol |
| Standard Protocols | |
|---|---|
| Click here to view our Standard Protocols |
发表文章
| Species | Application | Title |
|---|---|---|
Circ Res Yin Yang 1 Suppresses Dilated Cardiomyopathy and Cardiac Fibrosis Through Regulation of Bmp7 and Ctgf. | ||
Cell Mol Life Sci Omentin-1 drives cardiomyocyte cell cycle arrest and metabolic maturation by interacting with BMP7 | ||
Nanoscale Concentrated small extracellular vesicles from menstrual blood-derived stromal cells improve intrauterine adhesion, a pre-clinical study in a rat model. | ||
Front Mol Neurosci Tcf4 Controls Neuronal Migration of the Cerebral Cortex through Regulation of Bmp7. | ||
Front Pharmacol BMP-7 Upregulates Id2 Through the MAPK Signaling Pathway to Improve Diabetic Tubulointerstitial Fibrosis and the Intervention of Oxymatrine. | ||
BMC Complement Med Ther Huangqi decoction ameliorates kidney injury in db/db mice by regulating the BMP/Smad signaling pathway |